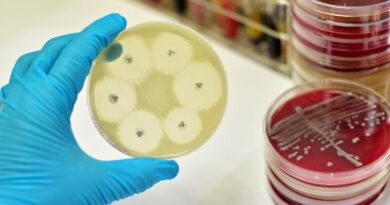

Jak Češi zvládají dobu koronavirovou? Pomáhají si a inspirují se!
Nikoho by ještě před pár týdny nenapadlo, že budeme procházet takovou zkouškou, jakou je karanténa a další související opatření. V této době se ukazuje, jak si jako národ stojíme – a není to vůbec špatné. Napříč republikou se nese vlna solidarity, pomoci a inspirace, kterou se snaží lidé navzájem povzbudit. Každý den tak narážíme na příklady těch, kteří se snaží pomoct ostatním se s touto nelehkou situací vyrovat. Zde jsou některé z nich, které stojí za vaši pozornost.
Na sociálních sítích najdete několik skupin, kde se propojují nejrůznější komunity. Ačkoliv je osobní kontakt více než nenahraditelný, v této chvíli nejspíš oceňujeme, že se skrze Facebook a další platformy můžeme propojit s ostatními, ať už je to rodina, přátelé, nebo třeba lidé, se kterými sdílíme stejné zájmy. To vše nám může pomoci tuto dobu přečkat a zároveň se obohatit o nové poznatky a zkušenosti.
Dobrovolníci z řad studentů lékařských fakult
Touhu pomáhat má v sobě téměř každý student medicíny. Dříve než vůbec propukla největší koronavirová krize, se proto studenti lékařských fakult šikovali na pomoc. Začalo to šesti sty dobrovolníky z Pražských lékařských fakult, postupně se však s rostoucím rizikem virové nákazy přidávalo více a více studentů. K dnešnímu dni má Facebooková skupina Dobrovolníci z řad studentů lékařských fakult více než 3 300 členů, kteří jsou připraveni nastoupit do nemocnic a bojovat s koronavirem v první linii. Mezi zdravotnická zařízení, kde dobrovolníci pomáhají, patří např. Fakultní nemocnice Královské Vinohrady, Nemocnice na Bulovce, Thomayerova nemocnice, Ústav pro péči o matku a dítě, a mnohé další.
Postupně dochází také k distribuci dobrovolnické pomoci i do menších mimopražských zdravotnických zařízení, kdy mají studenti možnost se zapojit v místě svého bydliště. Pomoc, kterou dobrovolníci poskytují, se týká také nouzových infolinek, hlídání dětí zdravotnického personálu FNKV, nebo třeba darování krve, ke kterému byli hromadně vyzváni. Mezi další aktivity našich studentů patří i šití roušek, a informování laické i odborné veřejnosti o onemocnění COVID-19.
“Pomáhám, protože můžu!”…vypomáháním jako sanitář, šitím roušek, hlídáním dětí zdravotnického personálu, pomocí v triážním stanu a mnoha dalšími aktivitami….ve Fakultní nemocnici Královské Vinohrady, v Nemocnici Jablonec nad Nisou, v Ústavu hematologie a krevní transfuze, ve Vítkovické nemocnici v Ostravě, v nemocnici Hořovice a mnohde jinde…pomáháš také? Sdílej to s ostatními! #pomáhámprotožemůžu #100forempomociVe videu vystupují kromě jednotlivých studentů 3. lékařské fakulty takéMUDr. David Marx- proděkan pro výuku 3. LF UKEva Soustružníková – sestra – Centrální příjem interních klinik FNKVDoc. František Duška – přednosta Kliniky anesteziologie a resuscitace FNKVProf. Petr Widimský – děkan 3. LF UK Prof. Ladislav Machala – Klinika infekčních nemocí 3. LF UK v Nemocnici na BulovceMUDr. Tomáš Šebek – Lékaři bez hranicDoc. Olga Džupová – Klinika infekčních nemocí 3. LF UK v Nemocnici na BulovceDěkujeme Vám všem a přejeme spoustu sil při dobrovolničení. Spolu to zvládneme!Pro studenty, kteří se chtějí ještě do pomoci zapojit: For students, who would like to help:www.trimed.cz/chcipomoci——————————————————————-“I help because I can!”…by helping as a health care assistant, by sewing facemasks, by looking after children of medical staff, by triaging patients in healthcare facilities and by doing many other activities….at the University Hospital Královské Vinohrady, at the Jablonec nad Nisou Hospital, at the Institute of Hematology and Blood Transfusion, at the Vítkovice Hospital in Ostrava, at the Hořovice Hospital and at lots of other places….are you also helping? Share it with others! #IhelpbecauseIcan #100formsofhelpApart from students from the Third Faculty of Medicine, you can also see in the video:MUDr. David Marx – vice-dean of the Third Faculty of MedicineEva Soustružníková – nurse – Central Admission of Internal Clinics of FNKVDoc. František Duška – head of the Clinic of Anaesthesiology and Resuscitation FNKVProf. Petr Widimský – dean of the Third Faculty of MedicineProf. Ladislav Machala – Clinic of Infectious diseases at the Bulovka HospitalMUDr. Tomáš Šebek – Doctors Without BordersDoc. Olga Džupová – Clinic of Infectious Diseases at the Bulovka HospitalThank you! We wish you a lot of strength while volunteering. Together we’ll manage!Pro studenty, kteří se chtějí ještě do pomoci zapojit: For students, who would like to help:www.trimed.cz/chcipomoc
Zveřejnil(a) 3. lékařská fakulta UK – Third Faculty of Medicine dne Pondělí 23. března 2020
Nadační fond PES V NOUZI
Během krizových situací se často zapomíná na pohodlí domácích mazlíčků. To se rozhodl změnit Nadační fond PES V NOUZI, který začal shánět dobrovolníky pro venčení psů, jejichž páníčci jsou v karanténě, případně se jedná o seniory, či dlouhodobě nemocné, kteří se bojí vycházet ven (či nemohou). Tato aktivita se setkala s obrovským zájmem a tak iniciativa vytvořila vlastní databázi. O každého mazlíčka je díky tomu i v době koronavirové krize postaráno.
„Obrovská vlna podpory a ochoty pomoci druhým, která se zvedla po zavedení různých protikoronavirových opatření, nás v nadačním fondu PES V NOUZI velmi dojala a překvapila. Je skvělé vidět, že lidí kromě vzájemné pomoci také myslí na pejsky, na které současná situace také dopadá minimálně ve formě omezené možnosti jít se vyvenčit se svými páníčky,“ řekla Eva Šteklová za nadační fond PES V NOUZI. Pokud jste v situaci, kdy nemáte možnost se o své mazlíčky postarat, nebo byste se sami chtěli zapojit a pomoct, pak se můžete přihlásit na Facebookové stránce PES V NOUZI nebo přímo přes formulář na stránkách této iniciativy.
Český červený kříž
Humanitární organizace Červený kříž funguje v dnešní České republice již jeden a půl století. Její dobrovolníci pomáhali při největších krizích a jinak tomu není ani v době koronavirové krize. Šijí roušky, pomáhají seniorům i handicapovaným, vzdělávají o prevenci, nebo i třeba venčí psi osob v karanténě. Dobrovolníků má nově již přes dva tisíce, vy se k Červenému kříži můžete připojit alespoň na sociální síti Facebook. „Lidé Červený kříž všeobecně znají, a obzvlášť v posledních týdnech jsme začali pociťovat obrovskou sílu a vůli dobrovolníků pomáhat. V duchu hesla Někdo jiný neexistuje. Pomoc druhým je na vás. vidíme, že ochota pomoci druhým je v nás a je skvělé vidět, kolik ochotných lidí je všude po republice,“ řekla Miroslava Jirůtková z Českého Červeného kříže.
Foto: archiv